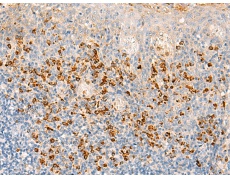
一抗

別 名: haptoglobin-related protein; HP; A-259H10.2
相關(guān)類別: 一抗
宿 主: Rabbit
抗 原: HPR
反應(yīng)種屬: Human
標 記 物: Unconjugate
克隆類型: rabbit polyclonal
技術(shù)規(guī)格
|
Background: |
This gene encodes a haptoglobin-related protein that binds hemoglobin as efficiently as haptoglobin. Unlike haptoglobin, plasma concentration of this protein is unaffected in patients with sickle cell anemia and extensive intravascular hemolysis, suggesting a difference in binding between haptoglobin-hemoglobin and haptoglobin-related protein-hemoglobin complexes to CD163, the hemoglobin scavenger receptor. This protein may also be a clinically important predictor of recurrence of breast cancer. |
|
Applications: |
ELISA, WB, IHC |
|
Name of antibody: |
HPR |
|
Immunogen: |
Synthetic peptide of human HPR |
|
Full name: |
haptoglobin-related protein |
|
Synonyms: |
HP; A-259H10.2 |
|
SwissProt: |
P00739 |
|
ELISA Recommended dilution: |
5000-10000 |
|
IHC positive control: |
Human tonsil and Human brain |
|
IHC Recommend dilution: |
40-200 |
|
WB Predicted band size: |
39 kDa |
|
WB Positive control: |
Human liver tissue lysate |
|
WB Recommended dilution: |
200-1000 |






 購物車
購物車 幫助
幫助
 021-54845833/15800441009
021-54845833/15800441009